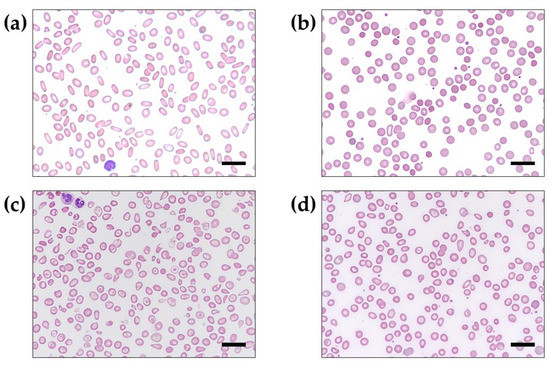

Abstract
Background: Hereditary hemolytic anemia (HHA) is defined as a group of heterogeneous and rare diseases caused by defects of red blood cell (RBC) metabolism and RBC membrane, which leads to lysis or premature clearance. The aim of this study was to investigate individuals with HHA for potential disease-causing variants in 33 genes reported to be associated with HHA. Methods: A total of 14 independent individuals or families diagnosed with suspected HHA, and in particular, RBC membranopathy, RBC enzymopathy, and hemoglobinopathy, were collected after routine peripheral blood smear testing. A custom designed panel, including the 33 genes, was performed using gene panel sequencing on the Ion Torrent PGM™ Dx System. The best candidate disease-causing variants were confirmed by Sanger sequencing. Results: Several variants of the HHA-associated genes were detected in 10 out of 14 suspected HHA individuals. After excluding those variants predicted to be benign, 10 pathogenic variants and 1 variant of uncertain significance (VUS) were confirmed in 10 individuals with suspected HHA. Of these variants, the p.Trp704Ter nonsense variant of EPB41 and missense p.Gly151Asp variant of SPTA1 were identified in two out of four hereditary elliptocytoses. The frameshift p.Leu884GlyfsTer27 variant of ANK1, nonsense p.Trp652Ter variant of the SPTB, and missense p.Arg490Trp variant of PKLR were detected in all four hereditary spherocytosis cases. Missense p.Glu27Lys, nonsense p.Lys18Ter variants, and splicing errors such as c.92 + 1G > T and c.315 + 1G > A within HBB were identified in four beta thalassemia cases. Conclusions: This study provides a snapshot of the genetic alterations in a cohort of Korean HHA individuals and demonstrates the clinical utility of using gene panels in HHA. Genetic results can provide precise clinical diagnosis and guidance regarding medical treatment and management for some individuals.
1. Introduction
Hereditary hemolytic anemia (HHA) is defined as a group of heterogeneous and rare diseases caused by defects of red blood cell (RBC) metabolism and/or defects of the plasma membrane, which leads to the lysis or premature clearance of these cells [1]. Representative laboratory findings comprise decreased haptoglobin, increased lactate dehydrogenase (LDH) and unconjugated bilirubin, reticulocytosis, abnormal RBC morphology, and often iron overload. The clinical manifestations include hemolytic anemia of variable degree, gallstones, jaundice, and splenomegaly. HHA is diagnosed according to persistent hemolytic anemia, laboratory testing, clinical evaluation, and family history. Overlaps in hematological and clinical characteristics exist among the different forms of HHAs, making differential diagnosis difficult, in particular for atypical and mild types. HHA has classically been categorized into three distinct types: RBC membranopathy [2], RBC enzymopathy [3], and hemoglobinopathy [4]. In the epidemiological study of hereditary hemolytic anemia in the Korean pediatric population, the incidence of newly diagnosed pediatric patients with HHA in the Republic of Korea from 2007 to 2016 was compared to that of an HHA cohort from 1997 to 2006 [5]. As a result, RBC membranopathies were observed to be the most common form of HHA (in an earlier period from 1997 to 2006, the incidence was 87.1%, compared to a later period from 2007 to 2016, in which it was 71.3%). When multi-gene panel sequencing was applied to these RBC membranopathies, the most frequent genetic variants in HS were found in SPTB, followed by ANK1 and SLC4A1 [6]. Significant increases in RBC enzymopathies (in the earlier period: 2.1%; in the later period: 6.2%) and hemoglobinopathies (in the earlier period: 4.2%; in the later period: 16.0%) were also found over that time. Korean individuals with RBC enzymopathy have distinct hemolytic symptoms such as relatively low Hb and haptoglobin levels but high LDH levels at very young ages.
On the other hand, none of the screening tests when used alone can reach a definitive diagnosis in 100% of cases, and some individuals remain undiagnosed even after extensive and complete investigations. For example, the eosin-5-maleimide (EMA) binding test and ektacytometry are tools used for the screening of membrane disorders, and when combined, they have the best performance in detecting HS [7]. New genetic approaches are currently being developed to automate the diagnostic yield and to expand molecular characterization. Genetic alterations may contribute to a considerable proportion of HHA individuals. At least 70 genes have been reported to be disease-associated. As such, a fast, effective genetic screening approach for HHA cases would be useful [8]. Recently, molecular testing advances have permitted definitive diagnoses in certain situations, and its use is increasing thanks to the development of next-generation sequencing (NGS) techniques [9]. The gene panel sequencing of multiple genes of interest is becoming more frequently applied in medical laboratories and is a rapid, cost-effective alternative to whole-genome sequencing or whole-exome sequencing. Benchtop sequencers have substantial time and cost savings over conventional Sanger sequencing and have the advantages of easy-to-interpret results, flexible sequencing options, and low cost compared to high-throughput sequencers [10]. The diagnostic success rate of NGS is higher when used in combination with conventional methods, together with a clinical classification and detailed symptoms of the individuals [11]. With a precise genetic diagnosis, physicians can provide genetic counseling and accurate treatment strategies for the management of HHA individuals and their family members. However, functional tests are often needed to confirm the pathogenicity of the detected variants [7].
The aim of this study was to identify pathogenic variants in 33 candidate genes associated with HHA in a cohort of individuals with various types of HHA and to illustrate the implementation of variant detection using gene panel sequencing after routine PB smear testing.
2. Materials and Methods
2.1. Specimen Collection and DNA Extraction
The annual number of routine PB smear examinations requested at the Department of Laboratory Medicine, Daejeon St. Mary’s Hospital (Daejeon, Republic of Korea) were 3534 in 2015, 4437 in 2016, 4677 in 2017, 4446 in 2018, and 4694 in 2019, respectively. If more than 50% abnormal or dysmorphic RBCs were observed upon the routine screening of peripheral blood smears, additional laboratory testing was performed for differential diagnosis. Briefly, an RBC autohemolysis test, RBC osmotic fragility test, and direct Coombs test were conducted to determine if hereditary elliptocytosis (HE), hereditary spherocytosis (HS), or hereditary stomatocytosis (HSt) was suspected. The high-performance liquid chromatography (HPLC) of hemoglobin (Hb) using an HLC-723G8 HPLC analyzer (Tosoh Co., Tokyo, Japan) was performed to characterize abnormal Hb variants such as HBA2, HbF, or other Hb fractions found commonly in beta thalassemia major (BTM) and beta thalassemia minor (BTm). A workflow for the screening and molecular diagnosis of suspected HHA is illustrated in Figure 1. Peripheral whole blood was collected from individuals with suspected HHA and their family members if available. Genomic DNA was extracted from peripheral blood leukocytes using a QIAamp DNA Blood Mini Kit (Qiagen, Hilden, Germany) according to the manufacturer’s protocols.

Figure 1.
A test workflow for the screening and molecular diagnosis of suspected hereditary hemolytic anemia. (+), positive for test; (-), negative for test.
2.2. Panel Design and Library Preparation
Thirty-three candidate genes have been reported to be associated with HHA and were selected for panel design based on PubMed literature retrieval (https://pubmed.ncbi.nlm.nih.gov/, accessed on 18 March 2020) and Online Mendelian Inheritance in Man search (OMIM, https://omim.org/, accessed on 18 March 2020). The 33 selected genes in a custom HHA panel are summarized in Table 1. Primers of overlapping amplicons covering the coding sequences of exons and exon–intron boundaries of each selected gene were designed automatically by Ion AmpliSeq Designer (https://www.ampliseq.com/, accessed on 30 March 2020). This produced 1063 amplicons, which were divided into two Ion AmpliSeq On-Demand Panel primer pools (Life Technologies; Thermo Fisher Scientific, Carlsbad, CA, USA). Amplicon libraries were prepared using Ion AmpliSeq On-Demand Panel primer pools and the Ion AmpliSeq Library Kit Plus (Life Technologies; Thermo Fisher Scientific) and custom designed primer pools, according to the manufacturer’s protocols. The libraries prepared for the custom HHA panel were partially digested, phosphorylated using the FuPa reagent, and then ligated with barcoded sequencing adaptors using the Ion Xpress Barcode Adapter 17–32 Kit (Life Technologies; Thermo Fisher Scientific). The library was purified and quantified with a Qubit 2.0 fluorometer (Invitrogen; Thermo Fisher Scientific, Waltham, MA, USA).

Table 1.
A list of 33 selected genes in a custom hereditary hemolytic anemia panel.
2.3. Gene Panel Sequencing and Bioinformatics Analysis
Gene panel sequencing using an Ion Torrent PGM™ Dx System (Life Technologies; Thermo Fisher Scientific) was carried out in individuals showing abnormal RBC morphology and positive for additional laboratory testing. Briefly, seven barcoded, multiplexed samples per chip were pooled in equimolar volumes at a concentration of 50 pM and loaded onto an Ion 318 v2 chip using the Ion Chef with the Ion 318 Chip Kit (Life Technologies; Thermo Fisher Scientific). Enriched template-positive ISPs were sequenced on an Ion 318 v2 chip using Ion Torrent PGM™ Dx System with the Ion PGM HI-Q SEQ Kit (Life Technologies; Thermo Fisher Scientific) according to the manufacturer’s guidelines. Data from Ion Torrent PGM™ Dx System runs were processed automatically using Torrent Suite 5.10 and Ion Reporter 5.10 (https://ionreporter.thermofisher.com/ir/, accessed on 16 June 2020) to generate sequence reads. Genome Reference Consortium Human Build 37 (GRCh37/hg19) was used as the reference sequence for mapping alignment. After sequence alignment and variant calling, variant allelic frequency (VAF) ≥ 0.01 in the gnomAD database (https://gnomad.broadinstitute.org/, accessed on 23 June 2020), intronic variants far away from the exon–intron boundaries, and synonymous variants predicted to cause no splicing error, estimated by SpliceAI (https://spliceailookup.broadinstitute.org/, accessed on 23 June 2020), were excluded from further interpretation. Sequence reads of the candidate genes were visualized using an integrated genomics viewer (IGV). Bidirectional Sanger sequencing of the polymerase chain reaction (PCR) products was performed to confirm candidate sequence variants using the BigDye Terminator v3.1 Cycle Sequencing Kit (Applied Biosystems, Foster City, CA, USA) and was resolved by capillary electrophoresis on a 3500xL Dx Genetic Analyzer (Applied Biosystems, Carlsbad, CA, USA). VarSome was used as an impact analysis tool, aggregator, and search engine for human genetic variation (https://varsome.com/, accessed on 30 June 2020). We placed verified variants into the following categories: benign (B), likely benign (LB), likely pathogenic (LP), pathogenic (P), and variant of uncertain significance (VUS), based on guidelines from the American College of Medical Genetics and Genomics (ACMG) and Association of Molecular Pathology (AMP) [12].
3. Results
3.1. Sequencing Quality Metrics and Overall Custom Designed Performance
In sequencing quality metrics for raw DNA sequencing data generated by the Ion Torrent PGM™ Dx System (Life Technologies; Thermo Fisher Scientific), 691 fragments with a target size of about 204.8 kb were produced simultaneously from about 1063 amplicons targeted on the exon–intron boundaries and exons of 33 HHA-associated genes. The custom-designed gene panel covered 94.2% of the bases in the target sites. Amplicon sizes, with an average amplicon size of 157 bp, ranged from 93 to 227 bp. For each specimen, coverage of the targeted site was about 97.1%, with a mean read depth of 164×. Target coverage read depth at 30× was >95%, with a mean read size of 177 bp. After initial variant calling by Torrent Suite 5.10 and Ion Reporter 5.10, more than 50 variants were identified in each specimen. After variants were filtered by variant type, VAF, and inheritance pattern, only one or two candidate variants from each specimen required confirmation by Sanger sequencing.
3.2. Molecular Diagnosis of the Suspected Hereditary Hemolytic Anemia
A total of 21,788 routine PB smear tests were examined between January 2015 and January 2019. Among them, 14 individuals (0.064%, 14/21,788) were suspected of HHA based on the results of abnormal RBC morphology as well as being positive upon additional laboratory testing. There were four HE, four HS, five BT, and one Hst. For example, PB smears revealed distinctly abnormal RBC morphologies in each individual with suspected HE (D099 in Figure 2a), HS (D131 in Figure 2b), BTM (D136 in Figure 2c), and BTm (D888 in Figure 2d).
Figure 2.
Results of peripheral blood smear examination in individuals with suspected hereditary hemolytic anemia (Wright–Giemsa stained; 1000× magnification). (a) Elliptocytes appeared oval or elongated, from slightly egg-shaped to rod or pencil forms in an individual with suspected hereditary elliptocytosis (D099). (b) Spherocytes appeared smaller and darker than normocytic red blood cells and lacked an area of central pallor in an individual with suspected hereditary spherocytosis (D131). (c) Severe hypochromic microcytic RBCs and poikilocytosis in a Cambodian individual with suspected beta thalassemia major (D136). (d) Mild to moderate hypochromic microcytic RBCs and poikilocytosis in a Chinese individual with suspected beta thalassemia minor (D888). Scale bar = 20 μm.
Gene panel sequencing was performed to identify molecular defects responsible for the suspected HHA individuals. From this analysis, several variants of the different HHA-associated genes were detected in 10 out of 14 suspected HHA individuals. In two out of four HE, a nonsense variant in EPB41 (reference transcript ID: NM_001166005.2:c.2112G > A/p.Trp704Ter) [13] and a missense variant in SPTA1 NM_003126.4:c.452G > A/p.Gly151Asp) were identified. In all four HS, a frameshift variant in ANK1 (NM_001142446.2:c.2642_2645dup/p.Leu884GlyfsTer27), a nonsense variant in SPTB (NM_001024858.3:c.1956G > A/p.Trp652Ter) [14], and a missense variant in PKLR (NM_000298.6:c.1468C > T/p.Arg490Trp) were detected. In four out of five BT, including one BTM and four BTm, missense (NM_000518.5:c.79G > A/p.Glu27Lys), splicing error (c.92 + 1G > T and c.315 + 1G > A), and nonsense (c.52A > T/p.Lys18Ter) variants in HBB were identified. No variant was detected in an individual with suspected HSt. All variant annotation information confirmed in this study is summarized in Table 2.

Table 2.
Candidate causative variants identified in 10 individuals with hereditary hemolytic anemia.
4. Discussion
The analysis of RBC morphology from PB smears is often the first indicator of the HHA under investigation and is still a fundamental test in the diagnostic algorithm. The detection of elliptocytes, spherocytes, or stomatocytes, although they may be present in differing and sometimes low numbers, addresses the extension of the diagnostic workflow toward an RBC membranopathy. In the situation of an RBC enzymopathy, the RBC morphology is usually reported to not be specific, but some abnormalities, although unremarkable, may still be suggestive of a particular deficiency such as prominent basophilic stippling in pyrimidine-5ʹ-nucleotidase deficiency or the presence of echinocytes in triose phosphate isomerase or PK deficiency [15]. However, the manual analysis of RBC morphology is hampered by a lack of standardization, is time-consuming, and is prone to some degree of subjectivity [16]. Cell shape classification and identification using artificial intelligence algorithms based on artificial neural networks may lead to a more rapid, effective, and standardized analysis of RBC morphology, but the challenge with these automated analyses is that artificial neural networks need to be customized, trained, and validated [17].
The clinical and genetic diagnosis of individuals with HHA may be extremely difficult to obtain. For some situations, the high symptom variability can be partially explained either by reduced penetrance or by high genetic heterogeneity and variable expressivity [18]. Significant progress has been made in discovering new disease-associated genes involved in red blood cell disorders, and increasing genetic heterogeneity underscores the difficulty of performing a very complex differential diagnosis [19]. It is appropriate in this context to consider gene panel sequencing. Several studies analyzed cohorts of patients ranging from 19 to 57 individuals using gene panel sequencing comprising a smaller gene set of 28 to 40 loci causative of some RBC membranopathies, RBC enzymopathies, sideroblastic anemia, Diamond–Blackfan anemia, and congenital dyserythropoietic anemia [20,21]. Russo and colleagues reported a diagnostic workflow for HHA, based on the development of two comprehensive gene sets, including 34 and 71 genes, respectively. As a result, they demonstrated that the multi-gene approach is valuable for guiding treatment as well as for achieving accurate and definitive diagnosis [8].
In this study, we demonstrate the feasibility of implementing broad-based, flexible, NGS-based gene panel sequencing to meet the clinical molecular testing need after routine PB smear testing. At the same time as reviewing patient medical records, three criteria are applied to ensure the successful implementation of this test workflow. First, if elliptocytosis or spherocytosis is observed by routine PB smear testing, additional testing including the RBC autohemolysis test, RBC osmotic fragility test, and Direct Coombs test are performed to screen for presumptive HE or HS. Second, if hypochromic microcytic RBCs or poikilocytosis are observed, Hb HPLC is performed to identify HBA2, HbF, or other Hb fractions, which are frequently observed in alpha or beta thalassemia. Third, if other severe dysmorphic RBCs persist for six months, gene panel sequencing for HHA is directly performed for genetic diagnosis. In our study, 14 individuals with suspected HHAs, including 9 RBC membranopathy and 5 hemoglobinopathy cases, were selected for gene panel sequencing. From this, several variants of the different HHA-associated genes were detected in 10 out of 14 suspected HHA individuals. After excluding variants predicted to be benign, 10 pathogenic variants and 1 variant of uncertain significance (VUS) were confirmed in 10 individuals with suspected HHA. Of these, the nonsense variant (p.Trp704Ter) in EPB41 and missense variant (p.Gly151Asp) in SPTA1 were identified in two out of four HEs. A frameshift variant (p.Leu884GlyfsTer27) in ANK1, nonsense variant (p.Trp652Ter) in SPTB, and missense variant (p.Arg490Trp) in PKLR were detected in all four HSs. Missense (p.Glu27Lys) and nonsense (p.Lys18Ter) variants and splicing errors such as c.92 + 1G > T and c.315 + 1G > A of the HBB were identified in four out of five BTs.
The most common RBC membranopathy is HS, followed by relatively uncommon conditions, such as HE and hereditary pyropoikilocytosis. Deleterious variants in genes ANK1, EPB41, EPB42, SLC4A1, SLC4A1, and SPTB are known to cause RBC membrane defects. In our study, nine individuals (four HEs, four HSs, and one Hst) were suspected of having an RBC membranopathy, and one HE and four HSs were observed to carry a pathogenic variant in one of the genes, having arrived at the diagnosis of RBC membranopathy on the basis of the conventional RBC autohemolysis test, RBC osmotic fragility test, and Direct Coombs test. The pathogenic nonsense variant p.Trp704Ter in EPB41 was found in one HE individual, and VUS in SPTA1 was detected in one HE individual. Although this p.Gly151Asp variant in SPTA1 was predicted to be pathogenic by in silico analysis (SIFT 0.001; PROVEAN -4.67; Mutation assessor 3.385), a functional study is required to establish causality for the clinical manifestation. RBC enzymopathies generally present with normal morphologies of RBCs, with normocytic normochromic hemolytic anemia in the PB [22]. Thus, if an individual shows non-immune hemolytic anemia without the clinical features of hemoglobinopathy or RBC membranopathy, an RBC enzymopathy can be clinically suspected. The diagnosis of an RBC enzymopathy is based on the genetic characterization of the defect at the DNA level and reduced specific enzyme activity [22]. Among RBC enzymopathies, G6PD deficiency, the most common red cell enzyme deficiency worldwide, may be missed in severe individuals that have chronic hemolysis with markedly high reticulocytosis or require blood transfusions. Unfortunately, RBC enzymopathies such as G6PD deficiency or PK deficiency were diagnosed, based on RBC enzyme level and external single gene testing, before our gene panel sequencing was applied during the study period. RBC enzyme evaluations for glucose-6-phosphate dehydrogenase (G6PD) and pyruvate kinase (PK) activity were referred to an external medical laboratory, GC Labs (Yongin, Republic of Korea), when a disease condition was suspected by a clinician. Usually, RBC enzymopathy cannot be diagnosed by PB smear testing alone, because RBC morphology is not specific in individuals with G6PD or PK deficiencies. Even though an RBC enzymopathy was not genetically diagnosed, a missense p.Arg490Trp variant of the PKLR was identified in clinically suspected HS (D034) [23,24]. Interestingly, concomitant HS and PK deficiencies were reported in a Spanish family with chronic hemolytic anemia [25]. Both a heterozygous missense p.Arg216Gln variant in SPTB and a heterozygous missense p.Arg569Gln variant of the PKLR were identified in the family member. After 6 years of clinical follow-up of the patients with HS, it was inferred that the chronic hemolytic anemia may be attributable to the SPTB mutation only, and not the influence of the concomitant PKLR. Moreover, only the family members with the SPTB mutation exhibited an ektacytometric profile characteristic of HS. To date, the co-existence of PKD and HS is very rare, and only a few cases have been reported [26,27,28]. However, heterozygous PKD may not modulate the clinical expression of HS.
In studies of hemoglobinopathy in the Korean population, the incidence of thalassemia in young Koreans has been shown to be increasing because of increasing rates of immigration or the increase in interracial marriages between Korean males and South East Asian females in recent years [29,30]. In particular, thalassemia is highly prevalent in Southeast Asia but rare in the Republic of Korea. However, with increasing Southeast Asian immigration, cases are increasing [29]. In a prospective, observational, multicenter study [31], eighteen multiethnic subjects and four Korean subjects were tested for α-globin and β-globin gene mutations. Within the multiethnic group, five subjects (1.5%) were α-thalassemia carriers, and six (1.9%) were β-thalassemia minor. The SEA deletion in HBA1 and HBA2, and the c. 126_129delCTTT (p.Phe42Leufs*19) mutation of HBB were the dominant inherited mutations. In our study, we had five BT individuals; one BTM with compound p.Glu27Lys and c.92 + 1G > T variants of the HBB was Cambodian, and the other BTm with heterozygous p.Lys18Ter HBB variant was Chinese. The last three Btms were Korean. Since the majority of Korean patients with hemoglobinopathy have BTm, hemolysis among these patients was not clinically significant [5]. On the other hand, hemoglobinopathy results in markedly aberrant Hb electrophoresis. Therefore, several Korean β-thalassemia patients were diagnosed based on family history and Hb electrophoresis, without genetic testing. However, since HBB gene sequencing is not very expensive in Korea, genetic tests were often performed when medical staff suspected β-thalassemia. By way of contrast, in the case of α-thalassemia, Hb electrophoresis test results are normal, and MLPA of HBA1/HBA2 can diagnose the most common deletions. In Korea, however, MLPA is not covered by the National Health Insurance System and is therefore very expensive. Thus, in Korea, the diagnosis of α-thalassemia is considered to be underestimated [5].
There are some inherent limitations to this study. (1) The studied sample size was quite small, even though several patients were genetically confirmed as HE, HS, or BT. Further studies with large sample sizes are required. (2) Only samples showing RBC morphology abnormalities screened by PB smear were genetically analyzed. Particularly, the possibility of RBC enzymopathy cannot be ruled out, because RBC morphology is not specific in RBC enzymopathy. (3) Only 33 genes related to IHA were estimated. It is not possible to exclude other IHA-associated gene abnormalities that are not included. Future molecular studies with larger multi-gene panel are needed for the comprehensive understanding of genetic diagnosis for IHA.
5. Conclusions
In summary, we designed an Ampliseq-based custom panel for the genetic screening of HHA individuals and detected 10 pathogenic variants and 1 VUS. Although a relatively limited number of individuals were selected in our cohort, the results provide an overview of molecular characteristics present in HHA. Mutation-negative individuals from this cohort will require additional tests to discover the potential molecular defects causing their HHA, although we cannot exclude the concept that genetic factors are not main causes of disease in these individuals.
Author Contributions
Conceptualization, J.P.; methodology, J.P.; software, N.K.; validation, J.P.; formal analysis, J.P.; investigation, T.Y.K.; resources, J.Y.H.; data curation, T.Y.K.; writing—original draft preparation, N.K. and T.Y.K.; writing—review and editing, J.Y.H. and J.P.; visualization, N.K.; supervision, J.Y.H. and J.P.; project administration, J.P.; funding acquisition, T.Y.K. and J.P. All authors have read and agreed to the published version of the manuscript.
Funding
This work was supported by the National Research Foundation of Korea (NRF) grants funded by the Korean government (MSIT; Ministry of Science and ICT) (No. 2020R1F1A1077316).
Institutional Review Board Statement
This study protocol was approved by the Institute Review Board (IRB) of the Catholic University of Korea (approval number: DC20ZASI0042; Date of approval: 9 June 2020).
Informed Consent Statement
Written informed consent was collected from all subjects for the clinical and molecular analyses and for the publication of any potentially identifiable images or data included in this study.
Data Availability Statement
Not applicable.
Conflicts of Interest
The authors declare no conflict of interest.
References
- Kim, Y.; Park, J.; Kim, M. Diagnostic approaches for inherited hemolytic anemia in the genetic era. Blood Res. 2017, 52, 84–94. [Google Scholar] [CrossRef] [PubMed]
- Mohandas, N.; Gallagher, P.G. Red cell membrane: Past, present, and future. Blood 2008, 112, 3939–3948. [Google Scholar] [CrossRef] [PubMed]
- Grace, R.F.; Glader, B. Red Blood Cell Enzyme Disorders. Pediatr. Clin. N. Am. 2018, 65, 579–595. [Google Scholar] [CrossRef] [PubMed]
- Sabath, D.E. Molecular Diagnosis of Thalassemias and Hemoglobinopathies: An ACLPS Critical Review. Am. J. Clin. Pathol. 2017, 148, 6–15. [Google Scholar] [CrossRef]
- Shim, Y.J.; Jung, H.L.; Shin, H.Y.; Kang, H.J.; Choi, J.Y.; Hah, J.O.; Lee, J.M.; Lim, Y.T.; Yang, E.J.; Baek, H.J.; et al. Epidemiological Study of Hereditary Hemolytic Anemia in the Korean Pediatric Population during 1997-2016: A Nationwide Retrospective Cohort Study. J. Korean Med. Sci. 2020, 35, e279. [Google Scholar] [CrossRef]
- Choi, H.S.; Choi, Q.; Kim, J.A.; Im, K.O.; Park, S.N.; Park, Y.; Shin, H.Y.; Kang, H.J.; Kook, H.; Kim, S.Y.; et al. Molecular diagnosis of hereditary spherocytosis by multi-gene target sequencing in Korea: Matching with osmotic fragility test and presence of spherocyte. Orphanet. J. Rare Dis. 2019, 14, 114. [Google Scholar] [CrossRef]
- Fermo, E.; Vercellati, C.; Bianchi, P. Screening tools for hereditary hemolytic anemia: New concepts and strategies. Expert Rev. Hematol. 2021, 14, 281–292. [Google Scholar] [CrossRef]
- Russo, R.; Andolfo, I.; Manna, F.; Gambale, A.; Marra, R.; Rosato, B.E.; Caforio, P.; Pinto, V.; Pignataro, P.; Radhakrishnan, K.; et al. Multi-gene panel testing improves diagnosis and management of patients with hereditary anemias. Am. J. Hematol. 2018, 93, 672–682. [Google Scholar] [CrossRef]
- Fermo, E.; Vercellati, C.; Marcello, A.P.; Keskin, E.Y.; Perrotta, S.; Zaninoni, A.; Brancaleoni, V.; Zanella, A.; Giannotta, J.A.; Barcellini, W.; et al. Targeted Next Generation Sequencing and Diagnosis of Congenital Hemolytic Anemias: A Three Years Experience Monocentric Study. Front. Physiol. 2021, 12, 684569. [Google Scholar] [CrossRef]
- Li, X.; Buckton, A.J.; Wilkinson, S.L.; John, S.; Walsh, R.; Novotny, T.; Valaskova, I.; Gupta, M.; Game, L.; Barton, P.J.; et al. Towards clinical molecular diagnosis of inherited cardiac conditions: A comparison of bench-top genome DNA sequencers. PLoS ONE 2013, 8, e67744. [Google Scholar] [CrossRef]
- Vives-Corrons, J.L.; Krishnevskaya, E.; Rodriguez, I.H.; Ancochea, A. Characterization of hereditary red blood cell membranopathies using combined targeted next-generation sequencing and osmotic gradient ektacytometry. Int. J. Hematol. 2021, 113, 163–174. [Google Scholar] [CrossRef] [PubMed]
- Richards, S.; Aziz, N.; Bale, S.; Bick, D.; Das, S.; Gastier-Foster, J.; Grody, W.W.; Hegde, M.; Lyon, E.; Spector, E.; et al. Standards and guidelines for the interpretation of sequence variants: A joint consensus recommendation of the American College of Medical Genetics and Genomics and the Association for Molecular Pathology. Genet. Med. 2015, 17, 405–424. [Google Scholar] [CrossRef] [PubMed]
- Shin, S.; Hwang, K.A.; Paik, K.; Park, J. A novel EPB41 p.Trp704* mutation in a Korean patient with hereditary elliptocytosis: A case report. Hematology 2020, 25, 321–326. [Google Scholar] [CrossRef] [PubMed]
- Shin, S.; Jang, W.; Kim, M.; Kim, Y.; Park, S.Y.; Park, J.; Yang, Y.J. Targeted next-generation sequencing identifies a novel nonsense mutation in SPTB for hereditary spherocytosis: A case report of a Korean family. Medicine 2018, 97, e9677. [Google Scholar] [CrossRef]
- Bain, B.J. Diagnosis from the blood smear. N. Engl. J. Med. 2005, 353, 498–507. [Google Scholar] [CrossRef]
- Constantino, B.T. Reporting and grading of abnormal red blood cell morphology. Int. J. Lab. Hematol. 2015, 37, 1–7. [Google Scholar] [CrossRef]
- Katz, B.Z.; Feldman, M.D.; Tessema, M.; Benisty, D.; Toles, G.S.; Andre, A.; Shtreker, B.; Paz, F.M.; Edwards, J.; Jengehino, D.; et al. Evaluation of Scopio Labs X100 Full Field PBS: The first high-resolution full field viewing of peripheral blood specimens combined with artificial intelligence-based morphological analysis. Int. J. Lab. Hematol. 2021, 43, 1408–1416. [Google Scholar] [CrossRef]
- Jamwal, M.; Aggarwal, A.; Palodhi, A.; Sharma, P.; Bansal, D.; Trehan, A.; Malhotra, P.; Maitra, A.; Das, R. Next-Generation Sequencing-Based Diagnosis of Unexplained Inherited Hemolytic Anemias Reveals Wide Genetic and Phenotypic Heterogeneity. J. Mol. Diagn. 2020, 22, 579–590. [Google Scholar] [CrossRef]
- Andolfo, I.; Russo, R.; Gambale, A.; Iolascon, A. New insights on hereditary erythrocyte membrane defects. Haematologica 2016, 101, 1284–1294. [Google Scholar] [CrossRef]
- Agarwal, A.M.; Nussenzveig, R.H.; Reading, N.S.; Patel, J.L.; Sangle, N.; Salama, M.E.; Prchal, J.T.; Perkins, S.L.; Yaish, H.M.; Christensen, R.D. Clinical utility of next-generation sequencing in the diagnosis of hereditary haemolytic anaemias. Br. J. Haematol. 2016, 174, 806–814. [Google Scholar] [CrossRef]
- Roy, N.B.; Wilson, E.A.; Henderson, S.; Wray, K.; Babbs, C.; Okoli, S.; Atoyebi, W.; Mixon, A.; Cahill, M.R.; Carey, P.; et al. A novel 33-Gene targeted resequencing panel provides accurate, clinical-grade diagnosis and improves patient management for rare inherited anaemias. Br. J. Haematol. 2016, 175, 318–330. [Google Scholar] [CrossRef] [PubMed]
- Koralkova, P.; van Solinge, W.W.; van Wijk, R. Rare hereditary red blood cell enzymopathies associated with hemolytic anemia—Pathophysiology, clinical aspects, and laboratory diagnosis. Int. J. Lab. Hematol. 2014, 36, 388–397. [Google Scholar] [CrossRef] [PubMed]
- Uenaka, R.; Nakajima, H.; Noguchi, T.; Imamura, K.; Hamaguchi, T.; Tomita, K.; Yamada, K.; Kuwajima, M.; Kono, N.; Tanaka, T.; et al. Compound heterozygous mutations affecting both hepatic and erythrocyte isozymes of pyruvate kinase. Biochem. Biophys. Res. Commun. 1995, 208, 991–998. [Google Scholar] [CrossRef] [PubMed]
- Beutler, E.; Gelbart, T. Estimating the prevalence of pyruvate kinase deficiency from the gene frequency in the general white population. Blood 2000, 95, 3585–3588. [Google Scholar] [CrossRef]
- Vives Corrons, J.L.; Krishnevskaya, E.; Montllor, L.; Leguizamon, V.; Garcia Bernal, M. Concomitant Hereditary Spherocytosis and Pyruvate Kinase Deficiency in a Spanish Family with Chronic Hemolytic Anemia: Contribution of Laser Ektacytometry to Clinical Diagnosis. Cells 2022, 11, 1133. [Google Scholar] [CrossRef]
- van Zwieten, R.; van Oirschot, B.A.; Veldthuis, M.; Dobbe, J.G.; Streekstra, G.J.; van Solinge, W.W.; Schutgens, R.E.; van Wijk, R. Partial pyruvate kinase deficiency aggravates the phenotypic expression of band 3 deficiency in a family with hereditary spherocytosis. Am. J. Hematol. 2015, 90, E35–E39. [Google Scholar] [CrossRef]
- Andres, O.; Loewecke, F.; Morbach, H.; Kraus, S.; Einsele, H.; Eber, S.; Speer, C.P. Hereditary spherocytosis is associated with decreased pyruvate kinase activity due to impaired structural integrity of the red blood cell membrane. Br. J. Haematol. 2019, 187, 386–395. [Google Scholar] [CrossRef]
- Zarza, R.; Moscardó, M.; Alvarez, R.; García, J.; Morey, M.; Pujades, A.; Vives-Corrons, J.L. Co-existence of hereditary spherocytosis and a new red cell pyruvate kinase variant: PK mallorca. Haematologica 2000, 85, 227–232. [Google Scholar]
- Hong, C.R.; Kang, H.J.; Lee, J.W.; Kim, H.; Kim, N.H.; Park, K.D.; Park, J.D.; Seong, M.W.; Park, S.S.; Shin, H.Y.; et al. Clinical characteristics of pediatric thalassemia in Korea: A single institute experience. J. Korean Med. Sci. 2013, 28, 1645–1649. [Google Scholar] [CrossRef]
- Park, E.S.; Jung, H.L.; Kim, H.J.; Park, S.S.; Bae, S.H.; Shin, H.Y.; Song, S.H.; Koh, K.N.; Lyu, C.J.; Lim, Y.T.; et al. Hereditary hemolytic anemia in Korea from 2007 to 2011: A study by the Korean Hereditary Hemolytic Anemia Working Party of the Korean Society of Hematology. Blood Res. 2013, 48, 211–216. [Google Scholar] [CrossRef]
- Lee, H.J.; Shin, K.H.; Kim, H.H.; Yang, E.J.; Park, K.H.; Kim, M.J.; Kwon, J.R.; Choi, Y.S.; Kim, J.N.; Shin, M.G.; et al. Increased Prevalence of Thalassemia in Young People in Korea: Impact of Increasing Immigration. Ann. Lab. Med. 2019, 39, 133–140. [Google Scholar] [CrossRef] [PubMed]
Disclaimer/Publisher’s Note: The statements, opinions and data contained in all publications are solely those of the individual author(s) and contributor(s) and not of MDPI and/or the editor(s). MDPI and/or the editor(s) disclaim responsibility for any injury to people or property resulting from any ideas, methods, instructions or products referred to in the content. |
© 2023 by the authors. Licensee MDPI, Basel, Switzerland. This article is an open access article distributed under the terms and conditions of the Creative Commons Attribution (CC BY) license (https://creativecommons.org/licenses/by/4.0/).


